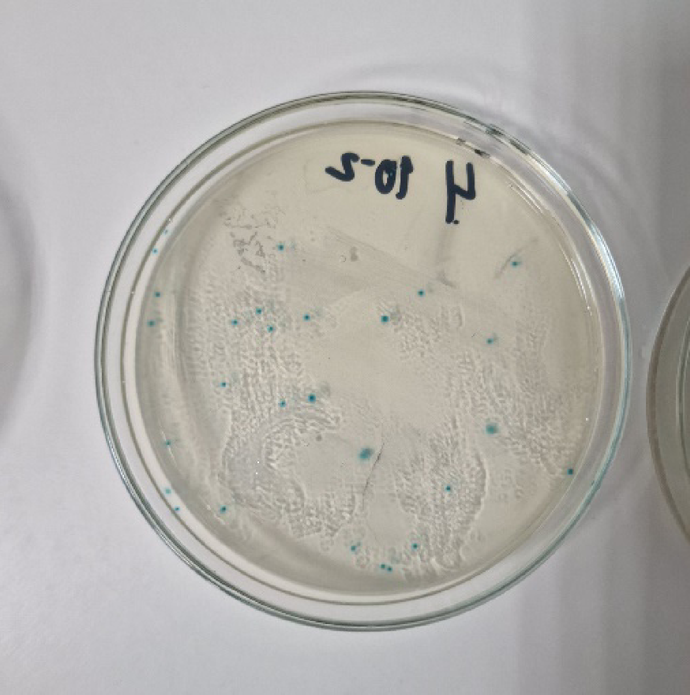
Fig. 5

Fig. 5

Typical colonies of β-glucuronidase-producing Escherichia coli on TBX agar. The sample was derived from a positive control in the study, plated from a 10⁻2 dilution.
Typical colonies of β-glucuronidase-producing Escherichia coli on TBX agar. The sample was derived from a positive control in the study, plated from a 10⁻2 dilution.